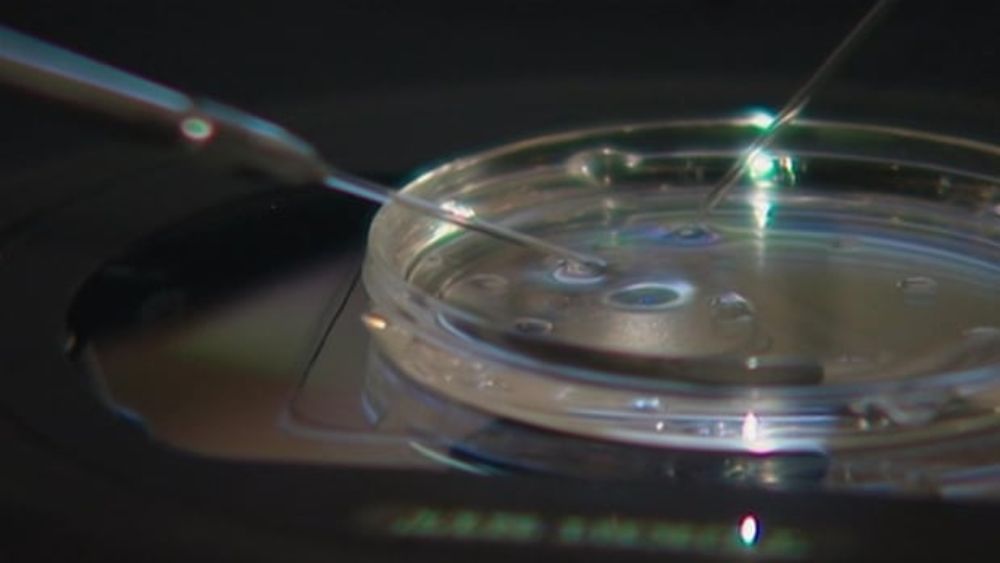

Advancing #PatientSafety - Learn more about the Digital Referrals and Orders program. www.doctorsofbc.ca/technology-d...
19.06.2025 18:30 — 👍 2 🔁 1 💬 0 📌 0@birindernarang.bsky.social
Sikh - He/Him Family Physician @GlobalBC - Medical Contributor @UBCFamPractice - Clinical Assistant Prof

Advancing #PatientSafety - Learn more about the Digital Referrals and Orders program. www.doctorsofbc.ca/technology-d...
19.06.2025 18:30 — 👍 2 🔁 1 💬 0 📌 0
Next endeavour.
Look forward to working with @bcfamilydocs.bsky.social over the next few years. 🙏🏽
AB is seeing its worst measles outbreak since 1979 – last week reaching 879 cases & rising.
Measles is highly contagious but preventable.
The vaccine is 97% effective. Protect yourself and your community.
THIS IS HUGE! An HIV PrEP drug in the form of a twice-yearly subcutaneous injection has JUST been APPROVED by the FDA. Lenacapavir was 99.9% EFFECTIVE at PREVENTING HIV in clinical trials. Let’s talk about that! 🧪🧵⬇️
18.06.2025 19:40 — 👍 4156 🔁 1299 💬 56 📌 39
Thanks to the Medical Post for publishing my 3-part series on what 🇨🇦 Canada can learn from 🇪🇸 Spain, a country where everyone has access to primary care.
✅ geographic-based centres
✅ team-based approach
✅ embedded in community
✅ patient-held records
canadianhealthcarenetwork.ca/how-spain-ma...
What a life of service.
Inspirational.
This is unacceptable, announcing a significant delay 1.5 weeks before a program is meant to go live.
Every day, week, month counts for patients struggling w/ their fertility journey.
It was early last year this program was announced.
Shameful.
#BCPoli
www.cbc.ca/news/canada/...
“You can’t fire me, I quit.”- Canadian politics.
06.01.2025 16:26 — 👍 1 🔁 0 💬 0 📌 0Six decades later, Star Trek may still be the only franchise based on the ideas that diversity is strength, justice is the measure of civilization, bounty is to be shared, peace is worth the price, and all these things can be achieved.
We need more shows that look ahead and find goodness.
This made me laugh more than it should have 😆
29.11.2024 19:08 — 👍 45 🔁 8 💬 3 📌 0
Here's why bird flu fears are intensifying. It's already in poultry and cattle. And a recent case of a Canadian teen being infected with #H5N1, likely from a wild bird, is raising fears that the virus is spreading more easily. www.npr.org/sections/sho... via @npr.org #AvianInfluenza
28.11.2024 19:29 — 👍 90 🔁 34 💬 7 📌 5
New paper alert!
@annfammed.bsky.social
Want to decrease emerg visits?
Provide primary care infrastructure supports so that patients can see a “within-group” provider (instead of a walk in clinic) after hours.
Decreasing fragmentation of care works!
www.annfammed.org/content/22/6...

Screenshot of Bhattacharya's interview with Gill on YouTube, entitled: Conversations with Jay Bhattacharya: Dr. Kulvinder Kaur Gill (anti-lockdown advocate) Caption on the screen (of Bhattacharya) reads: You have faced tremendous backlash from Canadian medical authorities, from the

Screenshot of GiveSendGo campaign for Gill featuring the video interview with Bhattacharya. Text reads: Legal Fund for Kulvinder Goal: CAD $300,000 Raised: $206,659 Campaign created by Kulvinder Kaur Campaign funds will be received by Kulvinder Gill MPC

Screenshot of CBC article title: X to pay legal bills for doctor warned over COVID tweets Company formerly known as Twitter says it's 'proud to defend' Brampton's Dr. Kulvinder Gill The Canadian Press Posted: March 25, 2024 Last Updated: March 25, 2024
In the midst of current #medsky Jay Bhattacharya discourse, here's a reminder that he crowdfunded for a Canadian doctor to cover the costs of her massive lawsuit.
She tried to silence critics of her anti-vax rhetoric and lost.
Bhattacharya then got Musk's attention and now he's paying her costs.
The sketch is flattering compared to the real thing 😆
27.11.2024 02:33 — 👍 1 🔁 0 💬 0 📌 0
Important PSA about alcohol mixed with methanol: avoid purchasing/consuming alcohol that isn’t legally produced or sold, particularly from informal settings eg market stalls,& check labels.
Can you tell fake alcohol from real? Why methanol is so hard to detect. globalnews.ca/news/1088658... #medsky

“An extensive, multi-agency public-health investigation into an avian influenza case involving a B.C. teenager has identified no additional cases nor evidence of human-to-human transmission. “
news.gov.bc.ca/31792

New B.C. Health Minister @josieosborne.bsky.social vows to revamp approach to overdose crisis after addictions portfolio is scrapped. www.theglobeandmail.com/canada/briti... via @theglobeandmail.com #ToxicDrugCrisis
25.11.2024 17:52 — 👍 9 🔁 6 💬 1 📌 1Here's my other one. go.bsky.app/GGoP5kf #starterpacks
25.11.2024 21:16 — 👍 26 🔁 5 💬 4 📌 2
Most Don’t Know That Alcohol Raises Cancer Risk www.annenbergpublicpolicycenter.org/most-dont-kn...
Only 40% "know that regularly drinking alcohol increases the risk of later developing cancer."
Want to make a big difference on health? Focus on the evidence-informed basics.
Here's one of my #starterpacks go.bsky.app/Vp39rtu
25.11.2024 20:58 — 👍 10 🔁 4 💬 2 📌 0Lol
Possible.
lol. Good luck.
20.11.2024 18:22 — 👍 0 🔁 0 💬 0 📌 0
It's no surprise to those who work in clinical medicine that RSV can cause severe illness in older adults.
"1 in 20 adults experienced all-cause hospitalization within 28 days."
Fortunately a vaccine is available that reduces severe infection.
tinyurl.com/3fbzwpmv #IDSky #MedSky
I heard that Andrew Tate tried to come stretch his awkward wings here and got banned in just one day.
Sorry, hate has no home here. Stay in the bad place, thanks.

#BREAKING
Canadian security agencies believePM Modi knew of India's plans to murder a Canadian citizen on Canadian soil.
www.theglobeandmail.com/politics/art...

Go Canucks!
20.11.2024 03:03 — 👍 4 🔁 0 💬 0 📌 0updated. go.bsky.app/GGoP5kf
20.11.2024 00:45 — 👍 35 🔁 8 💬 12 📌 1
Here is my segment from the weekend on Global BC.
Discussing Avian Flu case in BC & global rise in Measles with over 10 million worldwide cases last year, and an ongoing outbreak in New Brunswick.
globalnews.ca/video/108731...

Many online creators claim to be "health experts". Wondering how you can tell if they're legit? Before taking the info you see online at face value, slow down, think about where the info is coming from, and most importantly: be skeptical! youtube.com/shorts/BkGPn...
19.11.2024 15:52 — 👍 20 🔁 3 💬 1 📌 2